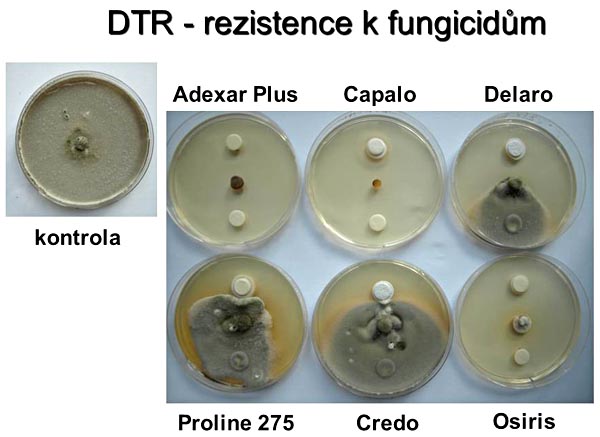
Obr. 6: Terč&iacute;kov&aacute; metoda testov&aacute;n&iacute; rezistence vůči fungicidům - Pyrenophora tritici-repentis (DTR)

Listové skvrnitosti na pšenici a ochrana proti nim
07. 06. 2018 Choroby Zobrazeno 2187x
Listové skvrnitosti na pšenici jsou, stejně jako ostatní houbové choroby obilnin, v posledních letech stále aktuální v důsledku nedostatečného střídání plodin, nezaorávání posklizňových zbytků (bezorebné technologie) a vzniku rezistence vůči fungicidům.
Původci a životní cyklus
Nejvýznamnějšími původci listových skvrnitostí na pšenici jsou v ČR i v ostatních evropských státech braničnatka pšeničná - Mycosphaerella graminicola (anam. Zymoseptoria tritici, dříve Septoria tritici), DTR - Pyrenophora tritici-repentis (anam. Drechslera tritici-repentis), a braničnatka plevová - Phaeosphaeria nodorum (anam. Stagonospora nodorum, dříve Septoria nodorum).
Od roku 2000 je ve VÚRV pravidelně sledováno zastoupení jednotlivých patogenů na území ČR. Většinou dominovala braničnatka pšeničná, pouze v letech 2000, 2003, 2004, 2011 a 2016 převažovala DTR. Braničnatka plevová byla na našem území velice hojná před více než 30 lety, v posledních letech je její výskyt spíše slabší. Postupné zvýšení výskytu braničnatky pšeničné na úkor braničnatky plevové může souviset se snížením emisí SO2 v ovzduší. Tento efekt byl pozorován i u některých patogenů dřevin.
Všechny tři houby patří do skupiny vřeckovýtrusých hub a mají obdobný životní cyklus (obr. 1). Přežívají na posklizňových zbytcích, kde přes zimu vytvářejí pohlavní plodnice (pseudothecia), z nichž jsou na podzim a hlavně na jaře uvolňovány askospory. Ty se šíří větrem a jsou zdrojem primární infekce. Na primárně napadených listech pšenice se pak tvoří nepohlavní stádium a pomocí konidií (u braničnatek pyknospor) se šíří choroba v porostu, jsou zdrojem sekundární infekce. U braničnatek jsou nepohlavní pyknospory uzavřené v pyknidách a spory se uvolňují z ústí za vlhka. Nejlépe se šíří v porostu rozstřikováním kapkami deště či rosy. U DTR je situace jiná, neboť konidie vznikají volně na listech a jsou neseny na dlouhých vláknech (konidioforech). K šíření v porostu stačí vítr, který přenese konidie z listu na list. Toto je důležité při prognóze vývoje chorob a rozhodování o chemickém ošetření.
Braničnatka pšeničná se při teplém podzimním počasí objevuje většinou již na mladých ozimech a mírná zima, která se v posledních letech stává již pravidlem, napomáhá množení inokula. Tomu přispívá také časté ponechání slámy na pozemku, což je další významný zdroj inokula. V jarním období jsou listy ozimů často pokryty lézemi plnými pyknid (obr. 2), první jarní výskyty braničnatky pšeničné však z hlediska škodlivosti ještě nemusí nic znamenat. Zásadní je vývoj počasí koncem května a začátkem června, který rozhoduje o rozšíření patogena v porostu.
Symptomy jednotlivých původců jsou někdy snadno zaměnitelné, zvlášť v počátečních fázích vývoje choroby. Typické pro DTR jsou světlehnědé skvrny s tmavým středem (obr. 3). Někdy ale obdobné skvrny mohou být i jiného původu a patogena není možno prokázat.
Stejně tak i braničnatka plevová (obr. 4), která tvoří na listech světle hnědé pyknidy, viditelné pouze pod mikroskopem, není pouhým okem bezpečně rozeznatelná. V pozdějších stádiích vývoje skvrny splývají a často se vyskytují všechny tři choroby na jednom listu zároveň.
Obr. 1: Životní cyklus Pyrenophora tritici-repentis (DTR)

Obr. 2: Mycosphaerella graminicola (braničnatka pšeničná) - symptomy v únoru 2015

Obr. 3: Pyrenophora tritici-repentis (DTR) - symptomy na jarní pšenici
Obr. 4: Phaeosphaeria nodorum (braničnatka plevová) - symptomy na ozimé pšenici
Ochrana
Ochrana proti listovým skvrnitostem spočívá v prvé řadě v agrotechnických opatřeních (zapravení posklizňových zbytků, osevní postup apod.), ale stěžejní je chemické ošetření ve stadiu sloupkování až metání, které je většinou prováděno opakovaně. Je registrována celá řada přípravků na bázi azolů a carboxamidů. Při opakované aplikaci je třeba dodržovat antirezistentní strategii, tj. střídat přípravky s různými účinnými látkami a zvážit počet ošetření.
Rezistence vůči fungicidům
Rezistence vůči fungicidům je v současné době hodně diskutována a braničnatka pšeničná spolu s DTR jsou dle FRAC (Fungicide Resistance Action Comittee) řazeny mezi organizmy se středním rizikem vzniku rezistence.
Nejlépe je v literatuře popsána rezistence vůči strobilurinům (QoI) u braničnatky pšeničné. Strobiluriny, které působí jako inhibitory mitochondriálního dýchání hub, byly v ČR používány od roku 1997. V rozsáhlejší studii (Drabešová et al. 2013) byl prokázán rapidní nárůst rezistence vůči strobilurinům v období 200522011 na území ČR. Tento jev byl obdobně popsán o několik let dříve v západní Evropě.
Testy rezistence vůči fungicidům jsou prováděny různými metodami. FRAC uvádí optimální metodiky pro jednotlivé patogeny a jednotlivé účinné látky (www.frac.info/monitoring-methods). Např. u Mycosphaerella graminicola je popsána metodika testů na agarových plotnách, kdy je měřena rychlost růstu izolátů při různých koncentracích účinné látky (tebuconazole), která je přidána do chladnoucího agaru před nalitím na Petriho misky. Pro QoI fungicidy je popsána metodika molekulárně genetického stanovení mutace zodpovědné za QoI rezistenci.
Pro několik účinných látek (boscalid, epoxiconazole, prochloraz a další) je pak doporučena metodika stanovení rezistence na mikrotitračních destičkách, kterou jsme zavedli i na našem pracovišti. Metoda je založená na měření absorbance v jednotlivých jamkách, kde je ředící řada o různých koncentracích účinné látky (obr. 5). Podle prvních výsledků je zřejmé, že některé izoláty vykazují náznak rezistence k účinné látce epoxiconazole. Test byl prováděn na izolátech braničnatky pšeničné pocházejících z jednoho pole na Rakovnicku, kde byl v jarním období masivní výskyt patogena a bylo podezření na rezistenci k fungicidům.
Někdy je pro testy používaná také terčíková metoda, která je založena na namoření sterilního terčíku fungicidem a jeho umístění na agarovou plotnu (obr. 6). Doprostřed misky je zaočkován patogen a je sledována rychlost růstu. Do spodní části misky je umístěn kontrolní terčík napuštěný sterilní destilovanou vodou. Výhodou této metody je, že je použit fungicid ve stejném složení, v jakém je aplikován na poli. Je však pravda, že je to pouze test laboratorní a rostlina reaguje jako celek odlišně od živného média. Ideální by bylo tedy tento test doplnit o polní postřik v podmínkách umělé infekce, aby byla zajištěna dostatečná přítomnost patogena v pletivech rostlin. Z obr. 6 je patrné, že testovaný izolát DTR reagoval na různé fungicidy rozdílně. Jednotlivé izoláty DTR se však od sebe lišily a po 14 dnech růstu při teplotě 20 °C vykazovaly různou intenzitu růstu. Nejnižší růst izolátů byl zaznamenán u přípravků Capalo, Adexar Plus a Osiris.
Obr. 5: Mikrotitrační destička - test rezistence vůči účinné látce epoxiconazole
Obr. 6: Terčíková metoda testování rezistence vůči fungicidům - Pyrenophora tritici-repentis (DTR)
Odolnost odrůd
Šlechtění na rezistenci vůči listovým skvrnitostem je komplikované vzhledem k polygennímu genetickému založení. Rezistence má kvalitativní i kvantitativní charakter.
U braničnatky pšeničné bylo popsáno 21 genů rezistence (Stb), z nichž Stb6 je jediný, který funguje na principu gen proti genu. Bylo též identifikováno 89 QTL oblastí a tato kvantitativní rezistence má většinou trvalejší charakter.
Na základě molekulárních studií bylo zjištěno, že DTR a braničnatka plevová jsou si příbuznější než obě braničnatky navzájem, i když je mezi nimi značná morfologická podobnost. DTR i braničnatka pšeničná produkují hostitelsky specifické toxiny Ptr ToxA, B, C, které jsou zodpovědné za vývoj symptomů na hostiteli a které jsou zároveň v interakci s dominantními geny hostitelské rostliny Tsn1, Tsc2, Tsc1.
Odolnost odrůd pšenice pěstovaných v ČR vůči komplexu třech původců listových skvrnitostí je uváděna v přehledu Seznam doporučených odrůd, který každoročně vydává ÚKZÚZ. U braničnatky plevové, kde je významné i napadení klasu, je navíc uváděna ještě hodnota odolnosti v klasu. Dle použité devítibodové stupnice 9–1 (9 odolná) se většina odrůd pohybuje v rozmezí 5–7, mezi odrůdami jsou v tomto směru minimální rozdíly.
Odolnost novošlechtění vůči třem původcům listových skvrnitostí je testována každoročně v kruhových testech v rámci činnosti Subkomise pšenice při ČMŠSA na několika stanovištích, hodnoty odolnosti materiálů se pohybují v rozmezí 4–7 dle stejné 9 bodové stupnice.
Závěr
Výskyt listových skvrnitostí na pšenici je každoroční a v posledních letech ho zvyšují některé faktory, jako je nedostatečné zapravování posklizňových zbytků, zavádění bezorebných technologií, opakované pěstování obilnin na stejném pozemku apod.
Fungicidních přípravků proti skvrnitostem je na trhu široká škála, ale pozor na vznik rezistence vůči fungicidům. Je třeba dodržovat antirezistentní strategii ve smyslu střídání různých fungicidů v průběhu vegetační sezony, používat vícesložkové fungicidy s účinnými látkami s rozdílnými mechanizmy účinku, používat fungicidy v doporučených dávkách atd.
Podrobné informace o této problematice lze najít na stránkách organizace FRAC (www.frac.info).
Seznam literatury je k dispozici u autorů článku.
Příspěvek vznikl za podpory MZe ČR projektu NAZV QJ1530373 a institucionálního příspěvku MZe RO0418.
foto: J. Palicová - 1,2, 5; I. Schmiedlová - 3, 4
Další články v kategorii Choroby











RSS
RSS